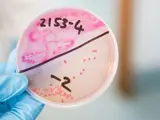
Science laboratory data services

The following is a list of the key published freshwater documents and research compiled to inform implementation of the National Freshwater Policy for Freshwater Management. The full list of publications is available here.
- NERMIN Report
- Access to water for the development of Māori land in the Bay of Plenty: Constraints and opportunities – Bay of Plenty Regional Council Environmental Publication 2025/04
- Nutrient, sediment and E.coli load reductions to meet desired Target Attribute State Outcomes within Freshwater Management Units in the Bay of Plenty – Bay of Plenty Regional Council Environmental Publication 2025/01 (Task 19 report)
- Groundwater Allocation Limits for the Bay of Plenty Region prepared for the Bay of Plenty Regional Council by Pattle Delamore Partners Jan 2025
- Estimates of baseline state and natural variability of NPS-FM attributes – Bay of Plenty Environmental Publication 2024/06
- Community engagement summary April to September 2023 – BOPRC Strategy & Policy Committee paper & attachments (page 19 here)
- Community engagement summary presentation to BOPRC Strategy & Policy Committee October 2023
- Expert Panel estimates of sources of key river contaminants in the Bay of Plenty region – Bay of Plenty Environmental Publication 2023/12
- Expert Panel summaries of river water quality and ecological attribute states under different land cover, land management and climate scenarios for catchments in the Bay of Plenty region – Bay of Plenty Environmental Publication 2023/11
- Lake Rotorua Science Review Summary – Bay of Plenty Environmental Publication 2023/09
- Expert Panel estimates of change to river water quality and ecological attributes under scenarios of climate change and land management – Bay of Plenty Environmental Publication 2023/08
- Expert Panel estimates of water quality and ecological attributes under Current State, Natural Land Cover and a hypothetical future land cover scenario – Bay of Plenty Environmental Publication 2023/05
- Ecological communities of springs in the Bay of Plenty – Bay of Plenty Environmental Publication 2023/02
- Baseline state, current state and trends in river attributes in the Bay of Plenty – Bay of Plenty Environmental Publication 2022/02
- Recommended steps to set minimum flows for ecological values in Bay of Plenty waterways – Bay of Plenty Environmental Publication 2022/03
- Module 7: Nutrient Management within the Lake Rotorua catchment – Bay of Plenty Council Report July 2022
- Te Hononga ‘The Confluence’: Regional Māori engagement plan for implementing the NPSFM 2020
- Discussion paper Reflecting tangata whenua values and interests on freshwater and freshwater ecosystems in the Rangitāiki, Kaituna-Pongakawa-Waitahanui water management areas Bay of Plenty December 2019
- Glug, Shpish, Slosh – all about fresh water in the Bay of Plenty 2018